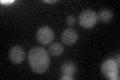
YHR103W
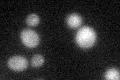
YHR103W
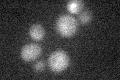
YHR103W

View description
Protein involved in the transport of cell wall components from the Golgi to the cell surface; similar in structure and functionally redundant with Sbe2p; involved in bud growth
Localization:
Intensity:
Fold change:
Significance:
-
C’ GFP library in SD
cytosol24.85 -
N' NOP1pr-GFP in SD

cytosol,punctate42.7485 -
N' TEF2pr-mCherry in SD

missing0 -
N' NATIVEpr-GFP in SD

cytosol25.9527 -
N' TEF2pr-VC and Cyto-VN in SD

#N/A0 -
C’ GFP library in SD+DTT
cytosol16.920.68No -
C’ GFP library in SD+H2O2

cytosol19.330.77No -
C’ GFP library in Starvation Media
cytosol17.650.71No -
C’ GFP library on the background of Pup2-DaMP

cytosol -
C’ GFP library on the background of CCT mutant

cytosol17.51340.704645Yes
